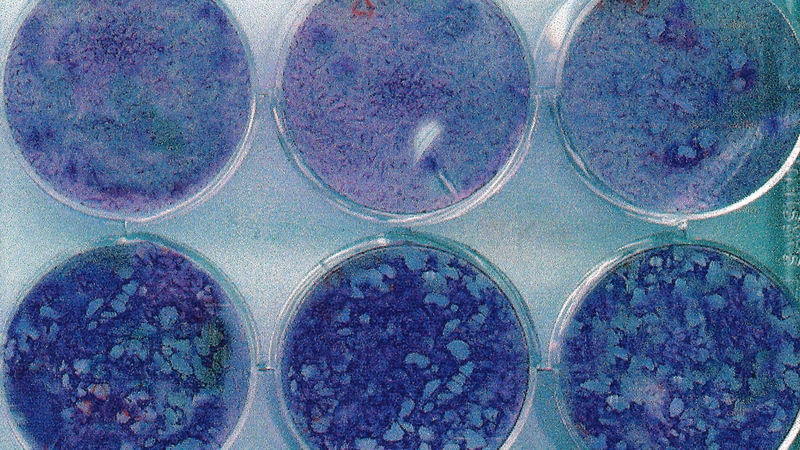
Virus varicella zoster có khả năng gây viêm não và biến chứng thần kinh

Dược sĩ Đại học có nhiều năm kinh nghiệm trong việc tư vấn Dược phẩm và hỗ trợ giải đáp thắc mắc về Bệnh học. Hiện đang là giảng viên cho Dược sĩ tại Nhà thuốc Long Châu.
Quỳnh Loan
05/03/2026
Mặc định
Lớn hơn
Biến chứng thủy đậu ở người lớn thường diễn tiến phức tạp hơn so với trẻ nhỏ do hệ miễn dịch suy giảm và nhiều bệnh lý nền đi kèm. Việc nhận biết sớm các dấu hiệu nguy hiểm sẽ giúp người bệnh chủ động điều trị và hạn chế rủi ro ảnh hưởng lâu dài đến sức khỏe.
Thủy đậu là bệnh truyền nhiễm do virus varicella zoster gây ra và thường được xem là lành tính khi xuất hiện ở trẻ em. Tuy nhiên, khi người trưởng thành mắc bệnh, diễn biến có thể nghiêm trọng hơn với nhiều nguy cơ tổn thương cơ quan nội tạng. Do đó, hiểu rõ những dấu hiệu cảnh báo và cách phòng ngừa đóng vai trò quan trọng trong việc bảo vệ sức khỏe cá nhân cũng như cộng đồng.
Ở người trưởng thành, bệnh thủy đậu không chỉ gây sốt và nổi mụn nước đơn thuần mà còn có thể dẫn đến nhiều biến chứng nghiêm trọng nếu không được theo dõi và điều trị đúng cách. Các biến chứng thường xuất hiện khi virus lan rộng hoặc khi hệ miễn dịch suy yếu.
Viêm phổi là một trong những biến chứng phổ biến và nguy hiểm nhất ở người lớn mắc thủy đậu. Người bệnh có thể xuất hiện triệu chứng khó thở, đau ngực, ho khan hoặc ho ra máu nhẹ. Tình trạng này đặc biệt dễ gặp ở người hút thuốc lá, phụ nữ mang thai hoặc người có bệnh nền về hô hấp.
Khi virus tấn công phổi, quá trình trao đổi khí bị ảnh hưởng dẫn đến nguy cơ suy hô hấp nếu không được điều trị kịp thời. Việc theo dõi sát các biểu hiện bất thường về hô hấp giúp phát hiện sớm biến chứng này.

Các nốt phỏng nước của thủy đậu nếu bị gãi hoặc chăm sóc không đúng cách có thể bị bội nhiễm vi khuẩn. Tình trạng này khiến vùng da đỏ, đau, sưng tấy và có thể để lại sẹo lâu dài. Trong trường hợp nặng, vi khuẩn có thể lan vào máu gây nhiễm trùng toàn thân.
Người lớn thường có thói quen sinh hoạt bận rộn nên dễ bỏ qua việc chăm sóc da đúng cách khiến nguy cơ nhiễm trùng tăng cao. Do đó, việc giữ vệ sinh da và tránh làm vỡ nốt mụn nước là yếu tố quan trọng giúp hạn chế biến chứng.
Virus varicella zoster có khả năng ảnh hưởng đến hệ thần kinh trung ương gây viêm não hoặc viêm màng não. Người bệnh có thể xuất hiện triệu chứng đau đầu dữ dội, rối loạn ý thức, co giật hoặc chóng mặt kéo dài.
Mặc dù không phải trường hợp nào cũng gặp biến chứng thần kinh nhưng đây là tình trạng nguy hiểm cần được xử lý sớm. Khi xuất hiện dấu hiệu bất thường liên quan đến thần kinh, người bệnh nên đến cơ sở y tế để được kiểm tra ngay.
Phụ nữ mang thai mắc thủy đậu có nguy cơ gặp biến chứng nặng hơn do thay đổi miễn dịch trong thai kỳ. Ngoài nguy cơ viêm phổi, mẹ bầu còn có thể đối mặt với ảnh hưởng đến thai nhi nếu nhiễm bệnh trong những giai đoạn nhạy cảm của thai kỳ.
Chính vì vậy, việc theo dõi sức khỏe thai phụ cần được thực hiện chặt chẽ dưới sự hướng dẫn của bác sĩ để hạn chế tối đa nguy cơ cho cả mẹ và bé.
Thủy đậu ở người lớn thường có diễn tiến phức tạp hơn so với trẻ em do nhiều yếu tố liên quan đến sức đề kháng, thói quen sinh hoạt và tình trạng sức khỏe nền.
Không giống trẻ nhỏ, hệ miễn dịch của người trưởng thành có thể phản ứng mạnh hơn khi virus xâm nhập dẫn đến phản ứng viêm lan rộng. Đây là một trong những lý do khiến bệnh diễn tiến nặng hơn và dễ xuất hiện các biến chứng toàn thân.
Nhiều người lớn mắc các bệnh lý mạn tính như tiểu đường, bệnh tim mạch hoặc có thói quen hút thuốc lá khiến cơ thể khó chống lại virus. Những yếu tố này làm tăng nguy cơ nhiễm trùng thứ phát, đồng thời kéo dài thời gian hồi phục sau khi mắc bệnh.

Thói quen xem nhẹ triệu chứng ban đầu cũng là nguyên nhân khiến bệnh diễn tiến nghiêm trọng. Một số người vẫn làm việc quá sức hoặc tự ý dùng thuốc khi chưa có chỉ định từ bác sĩ dẫn đến nguy cơ biến chứng cao hơn và khó kiểm soát tình trạng viêm nhiễm.
Người trưởng thành thường tiếp xúc với nhiều nguồn lây trong môi trường công việc đông người nên khả năng phơi nhiễm virus cao hơn. Khi cơ thể chưa có miễn dịch bảo vệ, bệnh có thể tiến triển nhanh và gây ảnh hưởng lớn đến sức khỏe tổng thể.
Hiểu rõ con đường lây lan giúp mỗi người chủ động phòng tránh và giảm nguy cơ mắc bệnh trong cộng đồng. Virus varicella zoster có khả năng phát tán nhanh, đặc biệt trong môi trường kín hoặc đông người.
Việc hạn chế tiếp xúc gần và đeo khẩu trang khi chăm sóc người bệnh là những biện pháp đơn giản giúp giảm nguy cơ lây lan.

Phòng bệnh luôn là giải pháp hiệu quả nhất để bảo vệ sức khỏe trước các bệnh truyền nhiễm. Áp dụng những biện pháp dự phòng từ sớm giúp giảm đáng kể nguy cơ mắc bệnh cũng như hạn chế biến chứng nặng.

Người lớn chưa từng mắc thủy đậu hoặc chưa tiêm phòng nên cân nhắc tiêm vắc xin phòng thuỷ đậu tại các cơ sở uy tín như Tiêm chủng Long Châu để giảm nguy cơ mắc bệnh. Việc tiêm phòng đúng lịch không chỉ bảo vệ bản thân mà còn góp phần hạn chế lây lan trong cộng đồng.
Hiện nay, hệ thống Tiêm chủng Long Châu được đông đảo người dân lựa chọn nhờ hệ thống cơ sở vật chất hiện đại, phòng tiêm đạt chuẩn an toàn và quy trình tiêm chủng được kiểm soát chặt chẽ theo hướng dẫn của Bộ Y tế. Vắc xin phòng thủy đậu tại đây gồm có Varivax (Hoa Kỳ) và Varilrix (Bỉ) đều có nguồn gốc rõ ràng, được bảo quản đúng điều kiện nhằm đảm bảo hiệu quả và độ an toàn tối ưu. Bên cạnh đó, đội ngũ bác sĩ và điều dưỡng có chuyên môn cao luôn sẵn sàng tư vấn, theo dõi trước và sau tiêm giúp người tiêm an tâm trong suốt quá trình bảo vệ sức khỏe.
Thủy đậu ở người trưởng thành có thể gây ra nhiều vấn đề sức khỏe nghiêm trọng nếu không được theo dõi đúng cách. Hiểu rõ các dấu hiệu cảnh báo và chủ động phòng ngừa giúp giảm nguy cơ diễn tiến nặng cũng như bảo vệ sức khỏe lâu dài. Nhận thức đầy đủ về biến chứng thủy đậu ở người lớn là bước quan trọng để mỗi người chủ động chăm sóc bản thân và gia đình trước bệnh truyền nhiễm này.
Dược sĩ Đại họcNguyễn Mỹ Huyền
Dược sĩ Đại học có nhiều năm kinh nghiệm trong việc tư vấn Dược phẩm và hỗ trợ giải đáp thắc mắc về Bệnh học. Hiện đang là giảng viên cho Dược sĩ tại Nhà thuốc Long Châu.